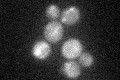
YGL021W

View description
Protein kinase; accumulation and phosphorylation are periodic during the cell cycle; phosphorylated in response to DNA damage; contains characteristic motifs for degradation via the APC pathway; similar to Alk2p and to mammalian haspins
Localization:
Intensity:
Fold change:
Significance:
-
C’ GFP library in SD

cytosol24.5 -
N' NOP1pr-GFP in SD

cytosol23.5969 -
N' TEF2pr-mCherry in SD

below threshold7.0209 -
N' NATIVEpr-GFP in SD

below threshold17.2829 -
N' TEF2pr-VC and Cyto-VN in SD

#N/A0 -
C’ GFP library in SD+DTT

cytosolN/AN/ANo -
C’ GFP library in SD+H2O2
cytosolN/AN/ANo -
C’ GFP library in Starvation Media

cytosolN/AN/AYes -
C’ GFP library on the background of Pup2-DaMP

cytosol -
C’ GFP library on the background of CCT mutant

cytosolN/AN/ANo
